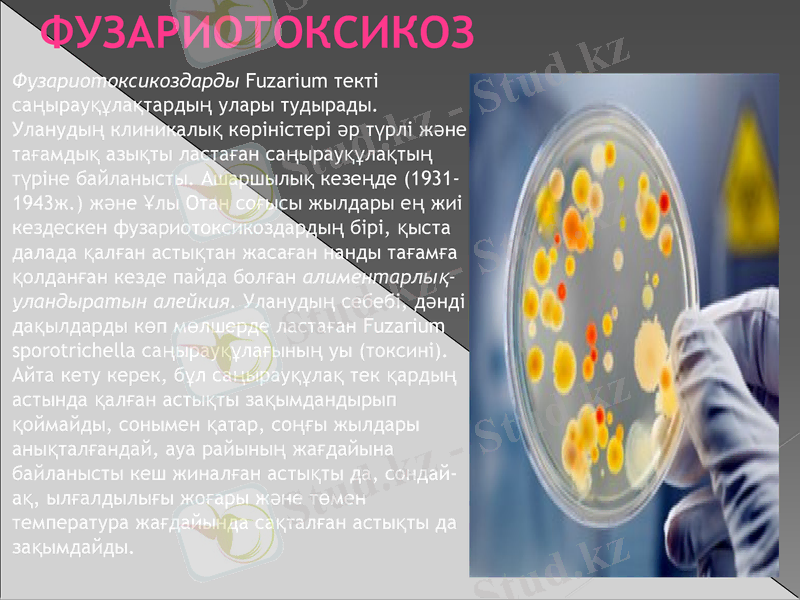
Slide 19

Мал өнімдерін ветеринариялық-санитариялық зерттеу: антидене түзу теориясы, аллергенді диагностика, балық пен бал микрофлорасы және тағамдық токсикоинфекциялар



Мал өнімдерін ветеринариялық - санитариялық зерттеу.
Антидене түзу теориясы. (Иммуноглобулин) .
Аллергенді диагностикумдар.
Балық, бал микрофлорасы.
Тамақ және азық токсикозы және қоздырғыштары.
СӨЖ

Жоспар:
1. Антидене түзу теориясы. (Иммуноглобулин) 2. Аллергенді диагностикумдар
3. Балық, бал микрофлорасы.
4. Тамақ және азық токсикозы және қоздырғыштары
5. Мал өнімдерін ветеринариялық - санитариялық зерттеу

Антиденелер немесе қарсыденелер - адам мен жануарлар организміне енген жат бөгде ірі молекулалы протеиндік заттарға (антигендерге) қарсы иммундық реакциялар нәтижесінде түзіліп, олардың зиянды әсерлерін жоятын протеиндік заттар (негізінен гамма-глобулиндер) ; адам және жылықанды жануарлар денесінде пайда болған антигендерге қарсы қан плазмасында түзілетін ақуыздық заттар. Антиденелер ағза иммунитетін күшейтуде маңызы үлкен.
Антиденелерді лимфоциттер мен плазмоциттер бөледі. Қарсьщенелерге тән қасиет - тек өздерінің түзілуіне әсер еткен антигендермен ғана әрекеттесіп, оларды жояды. Антиденелер - организмде қан сарысуы мен ұлпаларда жинақталады. Қарсыденелер антигендермен әрекеттесу сипатына қарай агглютининдер, гемолизиндер, бактериолизиндер, преципитиндер болып бірнеше топтарға бөлінеді.

Ф. Бернет теориясының негізін төрт ереже қалайды.
1. Лимфоидты ұлпада жасушалардың көптеген популяциялары болады. Ғалымның есебі бойынша адам организмінде лимфоидты жасушалардың саны 1012 жетеді. Әр клонның жасушалары иммуноглобулиндердің бір ғана вариантын жасап шығарады.
2. Мутацияға ұшыраған клондардың лимфоидты жасушаларының гетерогенді популяциялары иммуноглобулиндердің әртүрлі вариантгарын жасап шығарады. Иммуноглобулиндердің нақты бір антигенге үйлесімділігіне клонның генотипі жауапты болады. Ф. Бернеттің жорамалдауынша антигендердің жалпы саны 10 000 жуық болуы мүмкін. Бұл жағдайда лимфоидты популяцияларда белгілі бір антигенге антиденелерді түзуге алдын ала бейімделетін 10 000 клон болуы керек.
3. Антигендердің аз мөлшері өз клонының көбеюіне жэне антидене өндіруші жасушаларға айналуына ықпалын тигізеді. Бұл клонның пролиферациясының нәтижесінде бірнеше күн ішінде көптеген антидене өндіруші жасушалар пайда болып, антиденелер қан ағымын канықтыра бастайды.
4. Антигеннің көп мөлшері өзіне қарсы антиденелерді түзуге алдын-ала бейімделген жасушалардың клонын жойып жібереді. Бұл мәселе эмбриональдік кезеңде организмнің өз антигендеріне қарсы бағытталған лимфоидты жасушалардың талкандалуына әкеледі.

Антиденелерді ажырату әдісі
Антиденелерді ажырату мақсатында жоғары жылдамдықты центрифугалау әдісі қолданылады. Бұл тәсіл бойынша протеиндердің седиминтация (шөгу) жылдамдығы Сведбергтің (S) бірлігімен өлшенеді.
Центрифугалау нәтижесінде антиденелер екі негізгі топқа бөлінеді: шағын молекулалы антиденелер - 7S және үлкен молекулалы антиденелер 19S.
Бірінші топтың антиденелері электроффееграмманың гамма - глобулиндік, ал екінші топтағылар бета - глобулиндік фракцияларында болатындығы анықталды.
Антиденелер қан сарысуының ақуыздарының гаммаглобулин бөлігіне жатады. Гаммаглобулиндер қан сарсуының барлық ақуыздарының құрамының 15-20 пайызын құрайды, салмағы 10-20 гр жетеді. Антиденелер иммундық жауаптың себебінен пайда болғандықтан оларды - иммундыглобулиндер деп атайды. Олардың халықаралық белгісі Ig. Сонымен, антидене дегеніміз - антигендерге жауап ретінде түзілетін, антигендермен спецификалық байланысқа түсетін мүмкіншілігі бар, көп түрлі иммунологиялық жауап қайтаруға қатынасатын гаммаглобулиндер. Антиденелерді В-лимфоциттер және олардан тараған плазматикалық жасушалар бөліп шығарады

Иммуноглобулиндер 60-70 жылдары В. Портер мен Д. Эдельманның жұмыстарында антидене молекуларының құрылысы мен иммуноглобулиндердің негізгі фрагменттерінің рөлі толық шешілген; антиденелердің белсенді орталығының құрылысы мен орналасуы және әр кластағы иммуноглобулиндердің химиялық құрылысы мен айырмашылықтары көрсетілген үшін В. Портер мен Д. Эдельман 1972 жылы Нобель сыйлығына ие болған. Бұл аумақтағы жұмыстар 1980 жылдарда да белсенді жетілген: П. Берг, У. Гильберт, Ф. Сегнер жұмыстарында иммуноглобулиндердің түзілуін бақылаушы гендердің құрылымы белгілі болған. Молекулалық биологияның бұл аймағындағы жетімтігі де Нобель сыйлығына ие болған

Аллергенді диагностикумдар
Аллергия - (көне грекше: ἄλλος- басқаша, ergon - әрекет, жауап) - организмнің қоршаған ортаның кейбір әсерлеріне әдеттегіден тыс сезімталдығы. Аллергия терминін алғаш 1906 жылы Австрия педиаторлары К. Пирке мен Б. Шик енгізген. Аллергия туралы деректер көне заманнан белгілі. Гален (2 ғасыр) раушан гүлінен адам мұрынының бітіп қалатыны туралы жазған. Аллергияны туындататын заттарды аллергендер дейді. Аллергендер организмге сырттан түсетін (экзогендік) және организмнің өзінде өндірілетін (эндогендік) болып ажыратылады. Экзогендік аллергендерге өсімдіктердің тозаңдары, жануарлардың түбіті, қайызғағы, үй шаңы, кір жуғыш ұнтақтар, кейбір тағамдық заттар, дәрі-дәрмектер (новокаин, пенициллин, витаминдер т. б. ), микробтар мен вирустар, өндірістік өнімдер жатады.

Аллергиялық реакциялардың барысын белгілі аллерголог А. Д. Адо үш кезеңге бөлген:
1. Иммунологиялық кезең (антиген - антидене реакциясы) .
2. Патофизиологиялық кезең немесе ұлпалардың зақымдануы.
3. Патологиялық кезең немесе медиаторлардың бөлінуі

Аллергияны туынды иммунитеттің компоненті ретінде қарастыру керек, өйткені ол да басқа иммундық жауаптар сияқты денеге енген бөгде заттарға қарсы бағытталған организмнің жауабы болып табылады. Аллергиялық реакциялар қалыпты иммундық жауаптан күштірек (гиперергия) немесе әлсіздеу (гипергия) болып келуі мүмкін, ал кейде олардың нышаны мүлдем байқалмайды (анергия) .

Балық микрофлорасы
Балықтардың сыртқы қабатының микробтармен ластануы сулы ортаның микрофлорасының сапасы мен санына тікелей байланысты. Жылы теңіздерде оның көпшілік бөлігі мезофильді микроорганизмдер, ал орташа және салқын аймақтарда психрофильді микроорганизмдер болып есептеледі. Сонымен қатар, судың тұздылығына, микрофлораның галотолерантты, галофильді немесе галофильді еместігіне байланысты болады. Суда патогенді микрофлораның болуы көпшілік жағдайда, тазартылмаған немесе дұрыс тазартылмаған лас суды өзен көлдерге жіберудің нәтижесі болып саналады.
Мұндай жағдай, ішкі су бассейндерімен теңіз жағалауы суларына тән жағдай. Суға ішек таяқшалары, энтерококклар, сальмонеллалар және шигеллдер, Clostridium botulinum түсуі мүмкін
Балық еті, химиялық құрамы жағынан, сүт қоректілер етіне жақын. Оның құрамында белок, май және су көп болады, бірақ балық етінің жұмсақтығына, байланысты, оның денесінде микроорганизмдер өте тез таралады

Балықтың желбезегінде микробтар өте тез дамиды. Ауру балықты тауып, оны бөліп шығарып тастаса жақсы болар еді, бірақ бұл өте қиын. Балықты ұзақ сақтау кезінде ауру балықтар бұзылу көздері болып табылды. Кесу, өңдеу, сақтау кезінде балық әртүрлі микрофлорамен ластанады. Балықтың микрофлорасы құрамында көбінесе микрококкалар, сардиналар, споралық және споралық емес, сонымен қатар шіріту туғызатын таяқшалар кездеседі. Каспий теңізі бассейнінен ауланған балықтың ішегінде ботулинустың таяқшалары кездеседі. Мұндай балықтан дайындалған балық өнімдері уланудың ауыр түрі- ботулизмнің себепшісі болады.
Микробтардың балық белогына әсер еткенде аммиак, три- метиламин, күкіртсутек, индол т. б. жағымсыз иісті заттар түзіледі. Температура жоғарыланған сайын балықтыңда бұзылуы тездейді. Балықтың балғындығын желбезегінің түсіне қарап, иісіне және сыртқы түріне қарап білуге болады. Балықта жалғастыруша ұлпалардың негізгі белогы- коллаген, ол өте тұрақсыз болады, олардың бұзылу әсерінен балық жұмсарып кетеді, демек бұзылады. Жаңа ауланған балықпен салыстырғанда, мұздатылған балықта микробиологиялық процестер жүрмейді немесе баяу жүреді.

- Балық еті, химиялық құрамы жағынан, сүт қоректілер етіне жақын. Оның құрамында белок, май және су көп болады, бірақ балық етінің жұмсақтығына, байланысты, оның денесінде микроорганизмдер өте тез таралады.
- Қалыпты балық етінің ұлпаларында жануарлар еті сияқты, микроорганизмдер болмайды. Жаңа ауланған балықтың қабыршақтары мен желбезегінде Pseudomonas, Achromobacter, Vibrio (V. pazahaemolyticus, V. alginolyticuc) және басқа микроорганизмдер болады. Балықты ауланғаннан кейін психрофильдік микроорганизмдердің әсерінен балықтың өте тез бұзылу басталады.
- Сондықтан, жануарлар етімен салыстырғанда, балық еті тез бұзылғыш болып келеді.

Балық өнімдерінің микрофлорасы
Тазалық ережелерін сақтап алынған балық уылдырығы әдетте зарарсыздандырылған болады. Технологиялық өңдеу процесінде әртүрлі микробтармен ластанады. Соның нәтижесінде шіріту микроорганизмдері уылдырықтың сыртқы қабатына әсер етіп, бұзылуына себеп болады. Одан шыққан плазма тамақтық қасиеті жоғары, микроорганизмдердің көбеюіне қолайлы жағдай жасайды.
Уылдырықты өңдеу үшін қосылған тұздың концентрациясы бактерияға қарсы аздық етеді. Ас тұзының уылдырыққа әсерін жоғарылату үшін антисептиктер (0, 3%-ға дейін бура немесе 0, 1%-ға дейін уротропи) қосады. Пастерленген уылдырықта микрофлора құрамы төмен болады. 1 грамда 100-дей клетка немесе споралы таяқшалар, коккалар болады .

Бал микрофлорасы
Бал аса құнды диеаталық өнім. Табиғи балды, бал аралары гүл нәрінен өндіреді. Сонымен қатар бал аралары кейде балды өсімдік сөлінен немесе шыбын шіркейдің тәтті бөліндісінен өндіру мүмкін. Мұндай балды шіре балы деп атайды. Табиғи бал, тәтті, хош иісті сироп тәріздес сұйықтық немесе консистенциясы әр түрлі түйіршікті өнім.

Гүл және шіре балының химиялық құрамы, %
Су
16(15-20)
17, 5(17-18)
Құрғақ қалдық
84(80-85)
82, 5(82-83)
Инертті қанттар
75(65-80)
65, 5(65, 5-66, 8)
Басқа заттар . Сахароза
1, 9(1-5)
3, 5(2, 6-3, 9)
Декстриндер
5, 2(2-10)
11(10, 2-12)
Азотты заттар
0, 4(0, 1-1, 0)
0, 55(0, 5-0, 6)
Органикалық қышқыл
0, 3(0, 07-0, 54)
0, 37(0, 20-0, 54)
Минерарлды заттар
0, 35(0, 3-0, 4)
0, 95(0, 8-1, 0)
Құрамы
Гүл балы
Шіре балы

Базарға бал әр түрлі ыдыспен әкелінеді: ағаш күбі, алюмини құтысы, эмальданған ыдыс немесе жылтыратқан құмырамен әкелінеді. Мырышпен қапталған, сырланған, тот басқан және емен, қылқан жапырақты ағаштардан жасалған ыдыстар бал тасымалдауға қолданбайды.
Ветеринариялық санитариялық сараптау жұмысында балға әртүрлі заттардың қосылғанын анықтау қажет болатын жағдай кездеседі. Балдың жалпы көлемін ұлғайту үшін оған қант, ұн, крахмал немесе крахмал сірнесін және т. б. Қосады. Сонымен қатар араны қант сиропымен қоректендіреді. Мұндай бал жасанды балға жатады.
Араны қант сиропымен қоректендіру нәтижесінде алынған бал қант балы деп аталады. Оны табиғи бал есебінде сатуға рұқсат етілмейді.
Қант балының құрамы, араны қанша уақыт қант сиропымен қоректендіргеніне, оның концентрациясына және қышқыл қосылғанына байланысты. Бұл балдың ылғалдылығы 15-21, 1%. Осы көрсеткіш бойынша балдың жасандылығын анықтауға болмайды. Сонымен қатар глюкоза мен фруктозаның да мөлшеріне қарап та ажыратуға болмайды. Ал сахароза болса жасанды балда табиғи балға қарағанда көбірек.
Қант балын анықтау үшін мына көрсеткіштер есепке алынады: иісі, дәмі, консистенциясы, кристализациясы, гүл тозаңы, жалпы қышқылдылығы он пайыздан аспау керек. Жасанды бал сәуле жазықтығын оңға айналдырады.

Тағам токсикоинфекциясы
Тағамдық токсикоинфекция (астағы бактерия уыттарымен - токсиндерімен улану) - тағамда экзотоксин түзетін, негізінен шартты патогенді микроорганизмдермен қоздырылатын, нәжіс - ауыз механизмімен берілетін, жалпы уыттанумен, диспепсиялық белгілермен күрт басталатын ішек инфекциялары тобына жататын кесел. Азықтан жедел уланудағы негізгі патологиялық фактор тағамға түскен бактериялардың көбеюі барысында бөлінген экзотоксинге байланысты. Аурудың «инфекциялығы» ауру туғызушы удың микроорганизмдердің тіршілігі барысында бөлінген уыттылығында. Аурудың себебі организмнен тыс ортада көбейіп, көбеюі барысында экзотоксин бөлетін микроорганизмдер. Олар ботулизм бациллалары, алтын түстес стафилококк және шартты патогенді микроорганизмдердің көптеген тұқымдастықтары (протей, клебсиелла, цитробактер, серрация, энтеротоксинді стрептококтар т. б. ) Аталған микроорганизмдердің бәрі абиотикалық ортадағы көбею барысында энтро- және цитоксин синтездейді. Энтротоксин мен цитотоксин асқазан-ішек жолдарының эпителий торшаларын зақымдап, диспепсия, жалпы уланудың себебі болады.

Тағамдық токсикоинфекция туғызушы микроорганизмдер белгілі бір тағам түрлерінде, яғни олар үшін қолайлы қоректік орта болып табылатын тағам түрлерінде, сақталу температурасы 20-40°С деңгейінде бірнеше сағаттан бірнеше күнге дейінгі мерзімде экзотоксин түзіп жинақталады. Көп жағдайда тағамның түсі мен иісінің өзгермеуі де мүмкін. Жұқпа көзі дені сау тасымалдаушы, ауру адам немесе жануарлар. Шиқан, күбірткелі шыққан адам тағамды дайындау, өңдеу барысында асты залалдайды, жануарлардан қоздырғыштар сүт безі қабынғанда, іріңді қабыну ауруы бар жануарлар еті жеткілікті термиялық өңделмегенде түседі.
Фузариотоксикоз
Фузариотоксикоздарды Fuzarium текті саңырауқұлақтардың улары тудырады. Уланудың клиникалық көріністері әр түрлі және тағамдық азықты ластаған саңырауқұлақтың түріне байланысты. Ашаршылық кезеңде (1931-1943ж. ) және Ұлы Отан соғысы жылдары ең жиі кездескен фузариотоксикоздардың бірі, қыста далада қалған астықтан жасаған нанды тағамға қолданған кезде пайда болған алиментарлық-уландыратын алейкия. Уланудың себебі, дәнді дақылдарды көп мөлшерде ластаған Fuzarium sporоtrichella саңырауқұлағының уы (токсині) . Айта кету керек, бұл саңырауқұлақ тек қардың астында қалған астықты зақымдандырып қоймайды, сонымен қатар, соңғы жылдары анықталғандай, ауа райының жағдайына байланысты кеш жиналған астықты да, сондай-ақ, ылғалдылығы жоғары және төмен температура жағдайында сақталған астықты да зақымдайды.

Стафилококты токсикоз
Стафилококк бөліп шығарған энтеротоксин қоршаған ортада жақсы сақталады, жоғары және төмен температураға өте төзімді. Қышқылдар мен сілтілердің әсеріне өте төзімді, 100° С температураға дейін қыздырғанда өлмейді. Мұндай энтеротоксинді жою үшін 2, 5-3 сағат қайнатады немесе 120° С температурада 20 минутта жойылады.
Стафилококтар протеолитикалық ферменттер құрады, көмірсуларды ыдыратады, оттегінің қатысуымен әр түрлі дақтар түзеді: алтын сары, лимон - сары және ақ. Дақтың түріне қарай алтын тәріздес, лимон-сары, ақ стафилококк болып бөлінеді

Ботулизм
Ботулизм- тағамдық токсикоздың ауыр түріне жатады, көбіне адам өлімімен аяқталады. Өзінің аты «ботулизм»-деген латын тілінен алынған, «botulus» шұжық деген мағынаны береді, бұрындары бұл ауру тек шұжық жегендер арасында жиі кездескендіктен.
Ауру қоздырғышы Cl. botulinum 1896 жылы Голландтық Ван - Эрменгем шошқа етінің қалдығынан, көкбауырынан және осы етті жегеннен кейін, ауырып өлген адамдардың ішегінен анықтаған.
Cl. botulinum - спора түзгіш анаэроб, 6 антигенді түрлері бар: Cl. botulinum - А, В, С, Д, Е, F.

Сальмонеллез
Сальмонеллез - жедел ішек инфекцияларының бірі. Сальмонеллез тудыратын қоздырғыштардың түрі 700-ден асады. Олар көзге көрінбегенімен қоршаған ортада төзімді, азық-түлікте, соның ішінде жұмыртқа, құс еті, сүт өнімдерінде тез көбейе алады. Себебі ірі қара мал, құстар, шошқа, суда жүзетін құстар негізгі тасымалдаушылары.
Тасымалдаушылардан адам организіміне сальмонелла қоздырғышы осы тағамдарды пайдалану кезінде, яғни дайындау, тасымалдау, сату, тағамды өз дәрежесінде кулинарлық өңдеуден өткізбеген кезде, сақтау температурасы сақталмаған жағдайда жұғу қауіпі бар.

Ет және ет өнімдері Базарда сатуға әкелінген еттің иесі ветеринариялық куәлік, не анықтама тапсырады.
Ветеринариялық құжатта еттің індетті аурулар жоқ жерден, сау малдан алынғаны жөнінде және мал дәрігерлік байқаудан өткені жөнінде мәліметтер болуға тиіс. Егер ет бір ауданның әкімшілігінде сатылса, онда анықтама беріледі, ал егер әкімшілігі басқа ауданда сатылса онда малдәрігерлік куәлік берілуге тиіс.
Егер бұндай құжаттар жоқ болса, ет күмәнді деп есептелініп, бактериологиялық зерттеуден өткізеді
Қазіргі қабылданған ережелерге сәйкес ет ұшасы келесі тәртіппен зерттеледі: еттің сыртын және етті тіліп тексереді (түсі, консистенциясы, иісі) қоңдылығын, қансыздануын және жалпы патологиялық өзгерістерді анықтайды (бұлшық етті зақымдануы, қанталауы, ісіктер т. б. ) лимфа түйіндерін жарып тексереді, базарда сойыс өнімдерін зерттеудегі қажетті және ыңғайлы лимфа түйіндерді жарып тексереді. Шошқа және ірі қара ұшасын цистицеркозға зерттейді (тіл, жүрек, шайнау, мойын, қол, арқа, бел, сан бұлшық еттері) .

Шошқа ұшасын міндетті түрде трихинеллезге зерттеп, ұша буындарына, құрсақ шандырына ерекше назар аударады. Бас, жұтқыншақ, көмей лимфа түйіндерінде аздаған ғана патология лық өзгерістердің болуы (қанталауы, некроз) топалаңға күмәндандырады. Бұндай жағдайда, лимфа түйіндерін, ішкі ағзаларды, ұша сынамасын бактериоскопиялық және бактериологиялық зерттеулерге жібереді.
Ұсақ малдардың ұшасын тексергенде өкпе пневмониясының (өкпенің қабынуы) және плевритінің (плевраның қабынуы) бар жоқтығы еске алынады.
Өйткені, бұл аурулар екінші қатардағы салмонеллез тудыруы мүмкін. Сондықтан да, бұндай ұшалар бактериологиялық зерттеулерден өткізіледі.

Балық және бал өнімдерін ветеринарлық -санитарлық сараптау
Сараптауға балғын, мұздатылған, қақталған, кептірілген, тұздалған балықтар әкелінеді. Әкелінген өнімдерді органолептикалық зерттеу жүргізіледі, сатуға сапалы балық және балық өнімдері жіберіледі. Егер өнім сапасыз, жарамыз болса, онда бұл өнімді жойып, акт жасалады.
Балды ветеринарлық-санитарлық сараптау. Балға органолептикалық және (сыртқы түсіне, консистенциясына, иісі мен дәміне) лабораториялық зерттеу (қышқылдығы, су мөлшері, құрғақ қалдығы, диастаза саны, әртүрлі қоспалар) нәтижесі бойынша баға береді.

Ет және ет өнімдерін бактериологиялық әдістермен тексеру төмендегідей жағдайларда іске асырылады: - жіті түрде өтетін жұқпалы індетті ауруларға күдіктенгенде (топалаң, тырысқақ, қарасан т. б. ) ;
- аусылмен ауырған мал етінен өлі ұлпалар табылғанында;
- ішкі ағзаларында патологиялық өзгерістер байқалмаса да, шошқа обасымен, тілме, Ауески ауруымен ауырғанында;
- ет орташа қоңдылық категориясында болса да некробактериозбен (шірік тұяқ, бақай құрт, жегі) ауырған малдың ішкі ағзалары зақымданса;
- бұлшық еттерінде патологиялық өзгерістер байқалмаса да лейкозбен ауырған малдың бездері немесе ішкі ағзалары зақымданғанында;
- сақау, ақ ет (беломышечная болезнь) және кетозбен ауырған малдан алынған етте немесе ішкі ағзаларда патологиялық - анатомиялық өзгерістер кездескен жағдайда;

Ет өнімдерін бактериологиялық зерттеу
- жұқпалы ринотрахеит, парагрип-3, вирусты диарея (іш өту), жұқпалы аденовируспен ауырған малдың етінде және ішкі ағзаларында патологиялық- анатомиялық өзгерістер кездескен жағдайда;
- ауырған малдан алынған етте патологиялық- анатомиялық өзгерістер болғанында;
- онхоцеркоздың асқынған түрімен ауырған малдан алынған еттен іріңді-өлі үлпалар табылған жағдайда;
- желінсау, эндометрит, парометритпен ауырған қой, сиыр етін қолданғанда;
- себебіне қарамастан малды лажсыз сойған жағдайда;
- мал уланғанда;
- салмонеллезбен ауырған деп күдіктенген де және асқорыту ағзаларының аурулары байқалған жағдайда;
- тыныс алу ағзалары ауруларының асқынған түрінде;
- мал денесінің көп бөлігі күйген, бездері қанталап ісінген және септикалық үрдістің белгілері тері астында, ішкі ағзаларда, кілегей қабықтарында болып, қан құйылғаны байқалған жағдайда;

Сүт және сүт өнімдерін ветеринарлық - санитарлық сараптау
Сауда ережелерін сақтай отырып, сиыр, қой, бие, түйе сүті және сүт өнімдеріне ветеринарлық - санитарлық тұрғыда беріледі. Бұл өнімдерді ветеринарлық- санитарлық сараптау лабораториясының рұқсат қағазы болған жағдайды ғана рұқсат беріледі. Базарға сатуға тек жұқпалы аурулардан таза шаруашылықтардан алынған сүт қана жіберіледі. Ветеринарлық құжат бір ай көлеміне беріледі.
Сиыр сүті біркелкі консистенциялы, ақ немесе сарғыш түсті, үлпексіз, өзіне тән дәмі мен иісі болуы керек. Сүттегі май мөлшері 3, 2 %, тығыздығы 1, 034-1, 038 г/см 3, қышқылдығы 16-20 0Т. Қышқылдылығы 16 0Т төмен сүт сатуға жіберілмейді. Егер бруцеллезге күдікті аймақтардан әкелінген сүтті сақиналы реакция қою арқылы тексереді, егер сараптаудан өткен сүт оң немесе күдікті болса, бұндай сүтті ветеринарлық маманның бақылауымен жояды және екі данада акт жасалынады

Ауру және сау малдың етін анықтау
Органолептикалық зерттеу. Ол үшін малдың бауыздауына (бауыздау сызығы), ұшаның қансыздану дәрежесіне, гипостаз пайда болуына және лимфа түйініндегі өзгерістерге қөңіл аударады. Бауыздауының күйін зерттеу. Сау малды сойған кезде, оныңбауыздауытегіс емес, бұдыр болады және қан ол тұста көбірек жиналады, ал ауырып немесе арам өлген малдың бауыздауы керісінше тегіс болып келеді. Бауыздауының түсі айналасындағы ағзалармен бірдей. Бірақ та, бауыздалған жерді тегіс етіп шауып, тазалап қойған жағдайда, тек қана осы көрсеткіштер бойынша органолептикалық тұрғыдан тұжырым айту қиынға түседі.

Ұшаның қансыздану дәрежесін анықтау. Бұл көптеген факторларға байланысты болады (сою әдісі, қан тамырларының дұрыс кесілуі т. б. ) . Асып қойып сойған малдың қаны жатқызып сойғанға қарағанда жақсы ағады, жақсы қансызданады. Қансыздану дәрежесін: жақсы, қанағаттанарлық, нашар, өте нашар дәрежелері бойынша анықтайды. Қаннан жақсылап тазарған ұшаның еттерінде, қантамырларында қан болмайды. Арам өлген және өлгелі жатқан кезінде сойылған немесе ауырған малдың ұшасы қаннан өте нашар тазарады.
Қышқылдық ортаны анықтау (РН) РН-тың шамасы малды сояр кездегі бұлшық еттегі гликогеннің мөлшеріне, сонымен қатар, ондағы ферменттердің белсенділігіне байланысты болады. Сау малдың еті жетілуі үрдісі кезінде гликоген ферменттердің әсерінен сүт қышқылына дейін ыдырайды. Соның себебінен сутегі иондарының концентрациясы көбейеді де, ал РН -тың шамасы 7, 1 - 7, 2 ден 5, 6 - 5, 8 - ге дейін азаяды.
- Іс жүргізу
- Автоматтандыру, Техника
- Алғашқы әскери дайындық
- Астрономия
- Ауыл шаруашылығы
- Банк ісі
- Бизнесті бағалау
- Биология
- Бухгалтерлік іс
- Валеология
- Ветеринария
- География
- Геология, Геофизика, Геодезия
- Дін
- Ет, сүт, шарап өнімдері
- Жалпы тарих
- Жер кадастрі, Жылжымайтын мүлік
- Журналистика
- Информатика
- Кеден ісі
- Маркетинг
- Математика, Геометрия
- Медицина
- Мемлекеттік басқару
- Менеджмент
- Мұнай, Газ
- Мұрағат ісі
- Мәдениеттану
- ОБЖ (Основы безопасности жизнедеятельности)
- Педагогика
- Полиграфия
- Психология
- Салық
- Саясаттану
- Сақтандыру
- Сертификаттау, стандарттау
- Социология, Демография
- Спорт
- Статистика
- Тілтану, Филология
- Тарихи тұлғалар
- Тау-кен ісі
- Транспорт
- Туризм
- Физика
- Философия
- Халықаралық қатынастар
- Химия
- Экология, Қоршаған ортаны қорғау
- Экономика
- Экономикалық география
- Электротехника
- Қазақстан тарихы
- Қаржы
- Құрылыс
- Құқық, Криминалистика
- Әдебиет
- Өнер, музыка
- Өнеркәсіп, Өндіріс
Қазақ тілінде жазылған рефераттар, курстық жұмыстар, дипломдық жұмыстар бойынша біздің қор #1 болып табылады.



Ақпарат
Қосымша
Email: info@stud.kz